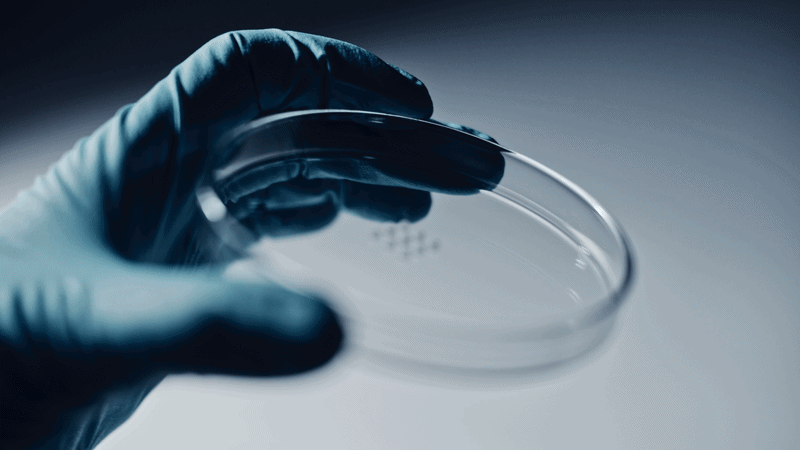

CLIENT – Cellink
PRODUCTION – Stommer Studios
Curious about what we could do for your brand?
Contact jonathan@stommer.se to learn more.
The Idea
A film series which shows the power and precision of CELLINK’s bioprinters. Each film highlights one system and the impact in real research and medical work. The films use a clean documentary style. Technology, human insight, and strong visuals work together to show how these machines shape future medicine and research. The tone stays calm and confident. The innovation speaks for itself.